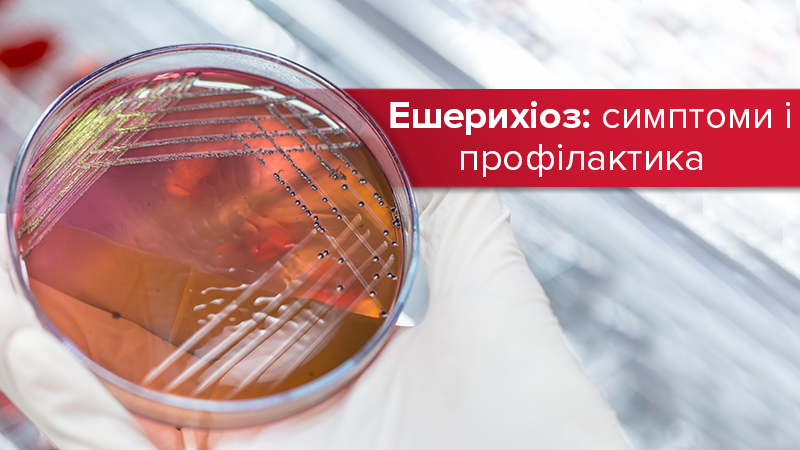
Эшерихиоз - что это, признаки и лечение заболевания

Об этом рассказали в пресс-службе Министерства здравоохранения.
Эшерихиоз – это бактериальное инфекционное заболевание, которое вызывают патогенные штаммы кишечных палочек. Возбудителем является бактерия Escherichia Coli.
Читайте также: Опасная инфекция листериоз в Украине: профилактика, симптомы и лечение
Климатические условия в тропиках способствуют возникновению выраженной лихорадки с ознобом и интоксикационными симптомами, но заболеть эшерихиозом можно и в Украине, употребляя некачественные продукты.
Симптомы эшерихиоза:
Симптомы и течение эшерихиоза зависят от вида возбудителя. Обычно, инфекция начинается постепенно и проявляется тошнотой, рвотой (до 3 раз в сутки), слабостью и спастическими болями в животе и обезвоживанием.
Реже протекает как недиарейное заболевание с поражением внутренних органов, как чисто органными (холецистит, холангит, инфекция мочевых путей, менингит и т.д.), так и системными с развитием сепсиса. Нередко такие патологические состояния расценивают как коли-инфекцию.
Профилактика эшерихиоза:
- не употребляйте продукты с истекшим сроком годности, используйте для приготовления блюда только свежие продукты питания;
- тщательно мойте руки до и после употребления блюда;
- при транспортировке и хранении пищевых продуктов используйте чистую упаковку (полиэтилен, контейнеры для пищевых продуктов и т.д.);
- не покупайте продукты у случайных лиц или в местах несанкционированной торговли;
- избегайте контактов с людьми, которые имеют признаки инфекционного заболевания.
При первых симптомах – обратитесь к врачу, самолечение может быть опасным для вашего здоровья!
Про сальмонеллез читайте по ссылке.
Другие новости, касающиеся лечения различных заболеваний, медицины в Украине, здорового образа жизни и питания, беременности и родов, открытий в области медицины и многое другое – читайте в разделе Здоровье.